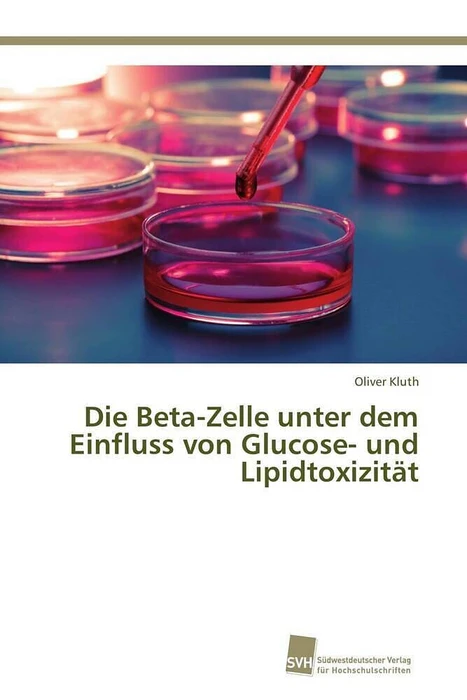

Wir verwenden Cookies und Analyse-Tools, um die Nutzerfreundlichkeit der Internet-Seite zu verbessern und für Marketingzwecke. Wenn Sie fortfahren, diese Seite zu verwenden, nehmen wir an, dass Sie damit einverstanden sind. Zur Datenschutzerklärung.
Die Beta-Zelle unter dem Einfluss von Glucose- und Lipidtoxizität
Details
Die Arbeit beschreibt die Auswirkungen von Glucose- und Lipidtoxizität auf die Funktion der Beta-Zellen von Langerhans-Inseln in einem diabetesresistenten (B6.V-Lep-ob/ob, B6-ob) sowie diabetesanfälligen (New Zealand Obese, NZO) Mausmodell. Es wurden molekulare Mechanismen identifiziert, die zum Untergang der Beta-Zellen in der NZO-Maus sowie zum Schutz der Beta-Zellen in der B6-ob-Maus beitragen. Durch die gleichzeitige Anwendung eines geeigneten Fütterungsregimes zur raschen Induktion eines Typ-2-Diabetes mit Beta-Zelluntergang in der NZO-Maus und der vergleichenden Analyse mit der B6-ob-Maus, konnten Signalwege gefunden werden, die entweder einen Diabetes verhindern oder auslösen. Mit Hilfe von ex vivo-Versuchen an isolierten Langerhans-Inseln beider Mausmodelle sowie in vitro-Versuchen an der Beta-Zelllinie MIN6 konnten die in vivo-Ergebnisse größtenteils bestätigt werden. Die Ergebnisse zu den Auswirkungen von Glucolipotoxizität auf die Beta-Zellen der verschiedenen Versuchsansätze werden in Zusammenhang mit aktueller Literatur vergleichend diskutiert.
Autorentext
Geboren am 23.10.1981 in Perleberg;Schulbildung:08/1994 - 06/2001 Marie-Curie-Gymnasium Wittenberge;Wehrdienst:09/2001 - 05/2002 Grundwehrdienst Prenzlau;Studium:10/2002 - 08/2008 Diplom Biochemie, Uni Potsdam;09/2008 - 07/2012 Promotion, Uni-Potsdam/DIfE;Beruf:seit 08/2012 Postdoc
Weitere Informationen
- Allgemeine Informationen
- GTIN 09783838137230
- Sprache Deutsch
- Genre Ökologie
- Größe H220mm x B150mm x T10mm
- Jahr 2015
- EAN 9783838137230
- Format Kartonierter Einband
- ISBN 978-3-8381-3723-0
- Veröffentlichung 12.07.2015
- Titel Die Beta-Zelle unter dem Einfluss von Glucose- und Lipidtoxizität
- Autor Oliver Kluth
- Gewicht 233g
- Herausgeber Südwestdeutscher Verlag für Hochschulschriften AG Co. KG
- Anzahl Seiten 144